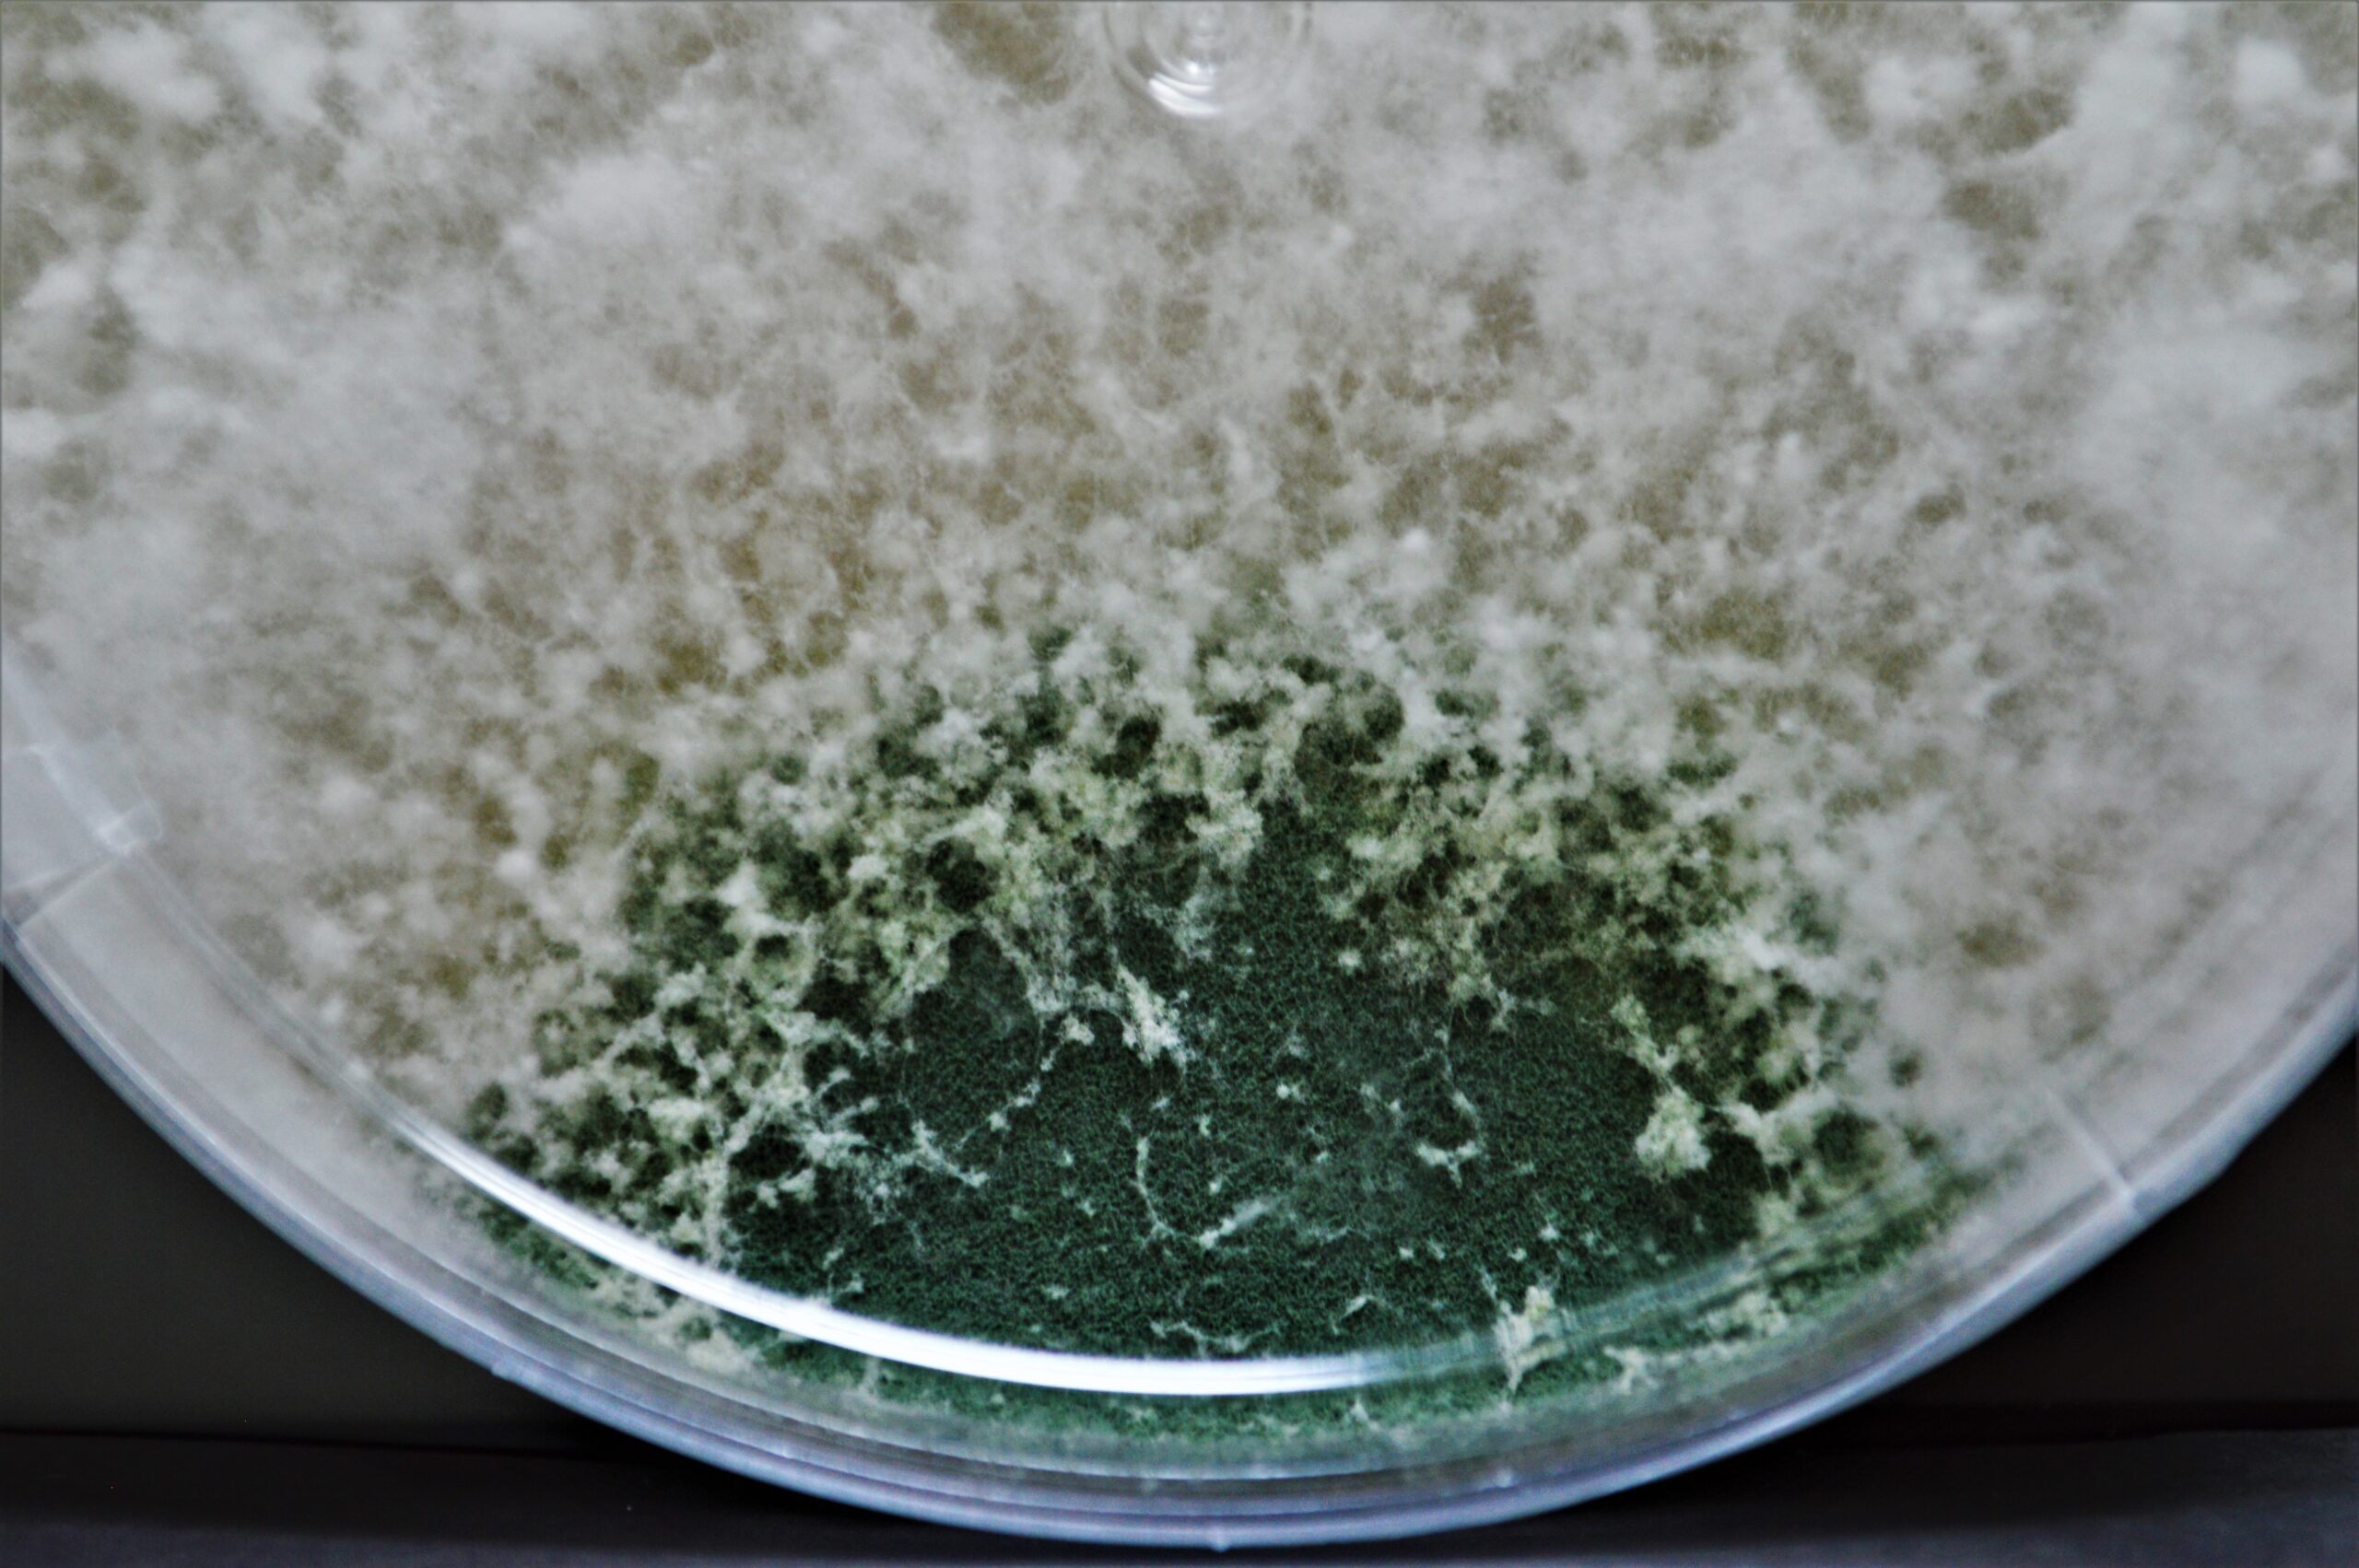

innovadoras
y responsable.
Fast Delivery
West & East coast dispatch
Return Policy
Support online 24 hours a day
Online Support
Online Support 24/7
Nuestras soluciones




Control biológico de precisión
Scientia impulsa la sostenibilidad agrícola con soluciones biológicas innovadoras. Nos especializamos en Control Biológico de Precisión: tecnologías limpias para el Manejo Integrado de Plagas que actúan con la dosis correcta, en el lugar y momento exactos. Protegemos los cultivos y el ambiente, fortaleciendo la productividad del agro latinoamericano.
Misión
Impulsar soluciones biológicas innovadoras para el Manejo Integrado de Plagas, promoviendo una agricultura limpia y sostenible que mejore la vida de productores y consumidores, genere valor a nuestros accionistas y potencie el crecimiento profesional de nuestro equipo.
Visión
Ser líderes en investigación, desarrollo e implementación de sistemas biológicos para el manejo integrado de plagas en Latinoamérica antes de 2028, garantizando a nuestros clientes soluciones competitivas, innovadoras, eficaces y sostenibles.
Cultivamos ideas,
cosechamos soluciones


Innovación biológica para tu producción agrícola
-
Trichowind
Trichogramma exiguum
Trichogramma exiguum Trichowind es un bioinsumo agrícola compuesto por avispas… -
Nemaguard
Steinernema feltiae y Heterorhabditis bacteriophora
Steinernema feltiae y Heterorhabditis bacteriophora Suspensión de juveniles infectivos (JI)… -
Persilys
Phytoseiulus persimilis
Phytoseiulus persimilis Depredador rojo especializado en Tetranychus urticae: rápido, voraz… -
Neocal
Neoseiulus californicus
Neoseiulus californicus Ácaro depredador flexible y resistente que regula ácaros… -
-
Vitryus
Orius insidiosus
Orius insidiosus Chinche depredador que patrulla flores y brotes, reduciendo…
Visión que
cultiva futuro
Trabajamos por liderar la transición hacia una agricultura innovadora y sostenible, impulsando productividad y protección ambiental.
Honestidad
Actuamos con transparencia y coherencia para construir relaciones de confianza duraderas
Etica profesional
Mantenemos altos estándares en cada decisión, garantizando responsabilidad y compromiso
Desarrollo profesional
Impulsamos el crecimiento de nuestro equipo para liderar una agricultura más sostenible
Trabajo en equipo
Colaboramos con propósito para innovar, crecer y alcanzar metas comunes

The Agriculture Process

Do You Have Any Questions ?
How can we protect organic farming ?
Cras turpis felis, elementum sed mi at arcu ?
Donec maximus, sapien id auctor ornare ?
Vestibulum nibh risus, eleifendulputate sem ?
Hear What Our Global Clients Say